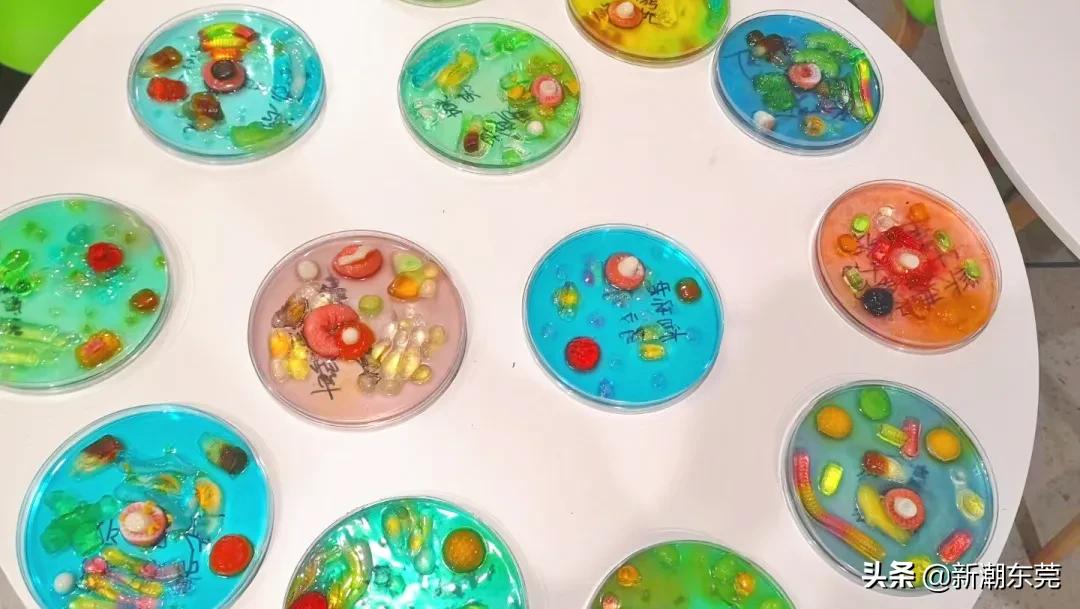
东莞外国语高中黑马,东莞黑马学校

又到最让家长操心的升学季了。
最近,东莞一所去年新办的高中很受家长关注。 去年首年招生生源质量就堪比东莞传统公办五大校;高一上学期期末统考,在全市40多所公、民办高中里面,东莞市海德双语学校总平均分和五大学科平均分全部跻身全市前茅,位居全市民办高中前三!

1
首年招生就成功出圈,成为大黑马!
去年,东莞中考放榜,各大高中成绩线出来之后,有一所全新民办学校非常抢眼。
这所学校就是 东莞市海德双语学校,位于东莞清溪镇,2020年9月正式开学。去年中考,东莞市海德双语学校公办班分数线672分,略低于东莞实验中学的678分,高于东莞外国语学校的665分。而且与全市民办高中相比, 海德双语学校的公费生招生比例占招生人数50%,位居全市第一!

民办线更加惊艳。 去年中考,东莞市海德双语学校民办分数线600分,在全市近20所民办高中里面排名第6名,仅次于东华、光明、翰林、南开、虎外这5所老牌名校。
据了解,海德双语学校首届高一实招308人,其中630分以上的254人,700分以上53人,平均分657分,总体生源质量堪比传统公办五大校。
首年招生就取得这样的好成绩,让东莞教育圈很惊讶。

2
厉害!期末平均分位居民办高中前三!
首年招生惊艳亮相,经过半年的教学,海德双语学校交出了更让人吃惊的成绩。
据了解,高一上学期期末统考,在全市40多所公、民办高中里面,东莞市海德双语学校 无论是总平均分还是语文、数学、英语、物理、历史五大学科平均分全部跻身全市前茅,位居全市民办高中前三!
在各级各类学科大赛中,东莞市海德双语学校33名学生获得 省级及以上奖项 ,占学生人数的10%。


学生风采
3
第1年就这么牛,是如何做到的?
一所全新的学校
开办第1年就取得的这么厉害的成绩
是如何做到的?
一流校长团队

总校长 黄赛勇
· 广东海德教育发展集团副总裁、中小学教育总监
· 东莞市海德双语学校总校长
· 英国利兹大学英语教育硕士
· 北京大学国际教育同学会理事
· 曾任虎门外语学校中学部(初中部、高中部、国际 部)教导主任、副校长、校长7年
· 曾就职东莞一中10年,担任高三教育教学工作8年,团委书记5年
· 曾就职台山一中4年
· 曾任美中国际教育集团学术校长、美中国际GIA学校创校中方校长

校长 梁萍
· 广东海德教育发展集团国际教育总监
· 英国利兹大学英语教育硕士
· 美国乔治亚州国际教师
· 澳大利亚翻译资格认可局专业翻译员
· 26年在中、英、美三国参与K-12国家课程、国际课程和双语课程的教学工作以及学校创建、课程设计和学校管理工作
· 曾任虎门外语学校国际部校长
· 曾就职东莞一中14年
· 全国优秀外语教师、南粤优秀教师

教学副校长/高中部校长 宋永成
· 省市级名师、省市级名师工作室主持人
· 省级学科优质课大赛特等奖、省级学科教学设计大赛一等奖
· 省级教育类重点规划课题主持人
· 国家级示范性高中年级管理、教研管理、德育管理、*党**务管理经验8年
· 曾在东莞一中工作15年,担任高三毕业班教学和管理工作近10年,擅长培育优等学生、扶助基础薄弱学生,所带年级高考成绩优异,大批学生国内外名牌大学
教师团队:硕博比例69.12%
一所好学校,离不开优秀的教师团队。
东莞市海德双语学校高中部汇聚全国优秀教师,省级骨干教师,市级优秀教师、教学能手、学科竞赛教练,及国内、国外顶尖名校毕业的青年才俊。这是一个高学历、多阅历,博学多识、经验丰富、屡获殊荣的教师团队。
高中一共38名老师,其中19人获得省级及以上荣誉。 其中硕士博士研究生学历占比近70%,平均教龄13.8年 。这个比例,在东莞的学校中,都算是非常高了。

多元课程,小班化教学
学校以“一切为了未来”为办学理念,坚持 小班制教学 (每班不超过40人) 、精细化管理 ,品质立校、特色兴校。大力推进全人教育,致力于培养面向未来的“十字型”人才。
高中部立足学生的核心素养,实施多元课程体系,以国家传统课程为基础,融入校本创新特色课程,凸显 中英双语、科创、思维、体艺技能 等特色教育,为学生的个性化发展和终身发展奠基。

部分课程一览

手球体验

橄榄球课

追风篮球

徒步远行

非遗醒狮

“我是歌手”

管弦乐团

师生茶座

文化碰撞

节庆派对
格物致知

探索未来

书院开蒙

诗词吟咏
东莞市海德双语学校已得到剑桥国际考评部的认证,成为 剑桥国际学校 (考试中心号:CX052)。米德中心高中部开设了剑桥IGCSE和A Level课程,为计划本科就读世界名校的高中生提供了充分的学术准备。英国高中课程(General Certificate of Education Advanced Level )简称A Level课程,它是英国的普通中等教育证书考试高级水平课程,也是英国学生的大学入学考试课程,相当于我国的高考。A Level课程证书被全球几乎所有英语授课的大学作为招收新生的入学标准。

4
今年高一招440人!公费生120人!
东莞市海德双语学校
2021年秋季高一年级计划招生440人
其中公费生招120人!
海德双语学校2021年秋季
高一入学意向登记已开启
各位家长可提前扫码登记
预约参观美丽校园





5
720°VR全景“云”探海德双语
扫描下面二维码
带你云探海德双语学校
学校的每一处
720°全方位呈现在你眼前

6
拥有雄厚的教育办学背景
海德教育拥有雄厚的教育办学背景
加上已开办的和即将开办的学校
未来三年,海德教育将有七园五校
提供3万+个优质学位




东莞市海德双语学校 大湾区第一所科创教育特色的高端双语学校,含幼儿园、小学、初中、高中和国际部(小学至高中),学校已于2020年9月开学,现有在读学生2000多名。67篇原创内容
公众号
开 设 学 段
小学 初中 高中
招 生 热 线
l 海德中心 l
0769-2318 8896、137 6319 8896
l 米德中心 l
0769-2360 8231、153 2295 8231
学 校 地 址
东莞市清溪镇清泉南路一号海德双语学校